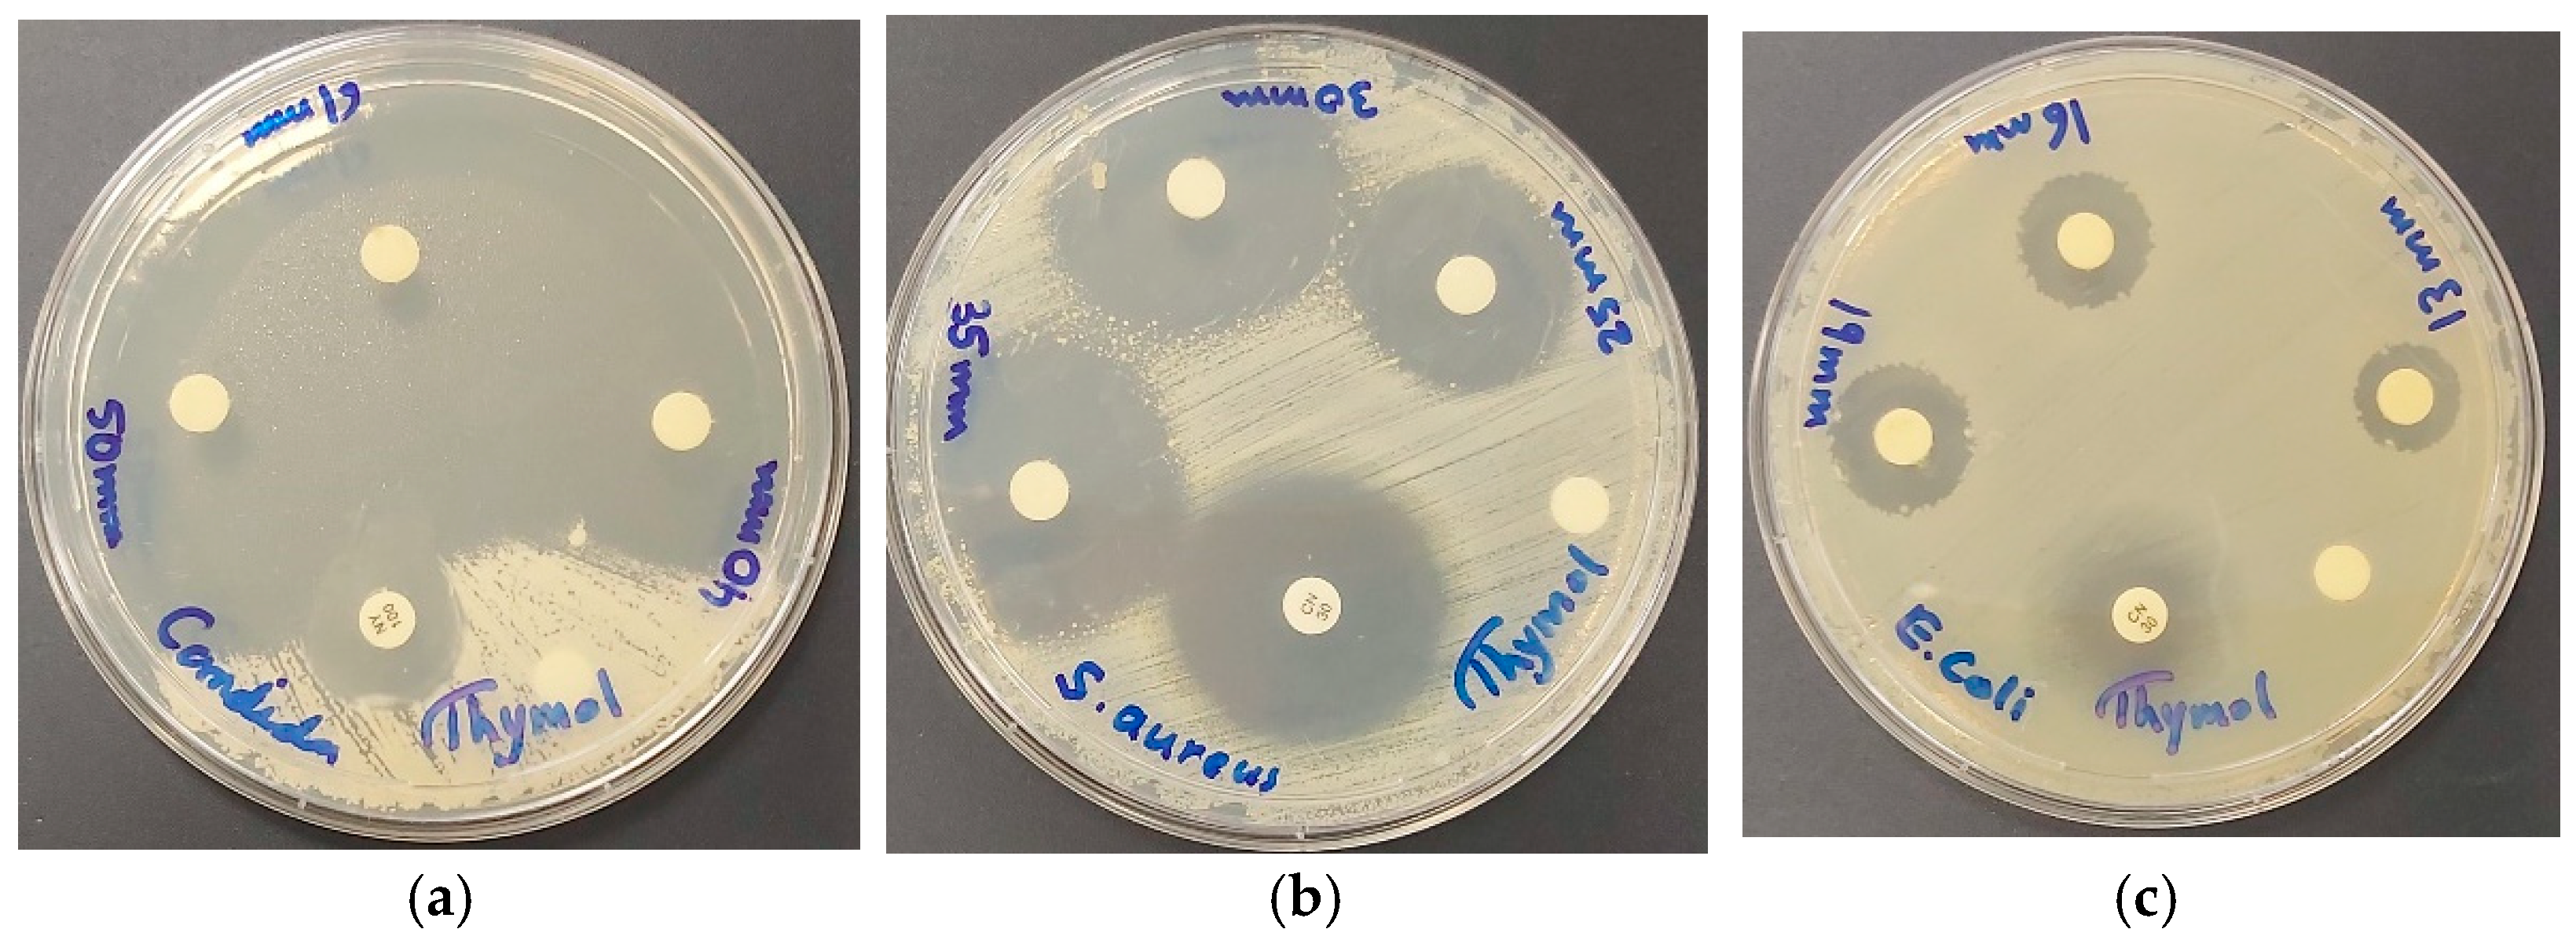
Ijms 25 04949 g009

Thymol, a Monoterpenoid within Polymeric Iodophor Formulations and Their Antimicrobial Activities
Abstract
1. Introduction
2. Results and Discussion
2.1. Morphological Examination and Elemental Composition of AV-PVP-Thymol-I2
2.2. Spectroscopical Characterization
2.2.1. Raman Spectroscopy
2.2.2. UV-Vis Spectroscopy
2.2.3. Fourier-Transform Infrared (FTIR) Spectroscopy
2.3. X-ray Diffraction (XRD)
2.4. Antimicrobial Activities of AV-PVP-Thymol-I2
3. Materials and Methods
3.1. Materials
3.2. Preparation of Aloe vera (AV) Extract
3.3. Preparation of AV-PVP-Thymol-I2
3.4. Characterization of AV-PVP-Thymol-I2
3.4.1. Scanning Electron Microscopy (SEM) and Energy-Dispersive X-ray Spectroscopy (EDX)
3.4.2. UV-Vis Spectrophotometry (UV-Vis)
3.4.3. Raman Spectroscopy
3.4.4. Fourier-Transform Infrared Spectroscopy (FTIR)
3.4.5. X-ray Diffraction (XRD)
3.5. Bacterial Strains and Culturing
3.6. Determination of Antimicrobial Activities of AV-PVP-Thymol-I2
3.6.1. Procedure for Zone of Inhibition Plate Studies
3.6.2. Disc Diffusion Method (DD)
3.7. Preparation and Analysis of Impregnated Sutures, Cotton Gauze Bandages, KN95 Masks, and Surgical Face Masks with AV-PVP-Thymol-I2 (11 µg/mL)
3.8. Statistical Analysis
4. Conclusions
Supplementary Materials
Author Contributions
Funding
Institutional Review Board Statement
Informed Consent Statement
Data Availability Statement
Acknowledgments
Conflicts of Interest
References
- Uddin, T.M.; Chakraborty, A.J.; Khusro, A.; Zidan, B.R.M.; Mitra, S.; Bin Emran, T.; Dhama, K.; Ripon, K.H.; Gajdács, M.; Sahibzada, M.U.K.; et al. Antibiotic resistance in microbes: History, mechanisms, therapeutic strategies and future prospects. J. Infect. Public Health 2021, 14, 1750–1766. [Google Scholar] [CrossRef]
- Baran, A.; Kwiatkowska, A.; Potocki, L. Antibiotics and Bacterial Resistance—A Short Story of an Endless Arms Race. Int. J. Mol. Sci. 2023, 24, 5777. [Google Scholar] [CrossRef] [PubMed]
- Romanescu, M.; Oprean, C.; Lombrea, A.; Badescu, B.; Teodor, A.; Constantin, G.D.; Andor, M.; Folescu, R.; Muntean, D.; Danciu, C.; et al. Current State of Knowledge Regarding WHO High Priority Pathogens—Resistance Mechanisms and Proposed Solutions through Candidates Such as Essential Oils: A Systematic Review. Int. J. Mol. Sci. 2023, 24, 9727. [Google Scholar] [CrossRef]
- Bloukh, S.H.; Edis, Z.; Shaikh, A.A.; Pathan, H.M. A Look Behind the Scenes at COVID-19: National Strategies of Infection Control and Their Impact on Mortality. Int. J. Environ. Res. Public Health 2020, 17, 5616. [Google Scholar] [CrossRef] [PubMed]
- Mulani, M.S.; Kamble, E.E.; Kumkar, S.N.; Tawre, M.S.; Pardesi, K.R. Emerging Strategies to Combat ESKAPE Pathogens in the Era of Antimicrobial Resistance: A Review. Front. Microbiol. 2019, 10, 539–563. [Google Scholar] [CrossRef]
- Mahoney, A.R.; Safaee, M.M.; Wuest, W.M.; Furst, A.L. The silent pandemic: Emergent antibiotic resistances following the global response to SARS-CoV-2. iScience 2021, 24, 102304. [Google Scholar] [CrossRef]
- Barranco, R.; Du Tremoul, L.; Ventura, F. Hospital-Acquired SARS-Cov-2 Infections in Patients: Inevitable Conditions or Medical Malpractice? Int. J. Environ. Res. Public Health 2021, 18, 489. [Google Scholar] [CrossRef] [PubMed]
- Ranney, M.L.; Griffeth, V.; Jha, A.K. Critical supply shortages—The need for ventilators and personal protective equipment during the Covid-19 pandemic. N. Engl. J. Med. 2020, 382, e41. [Google Scholar] [CrossRef]
- Félix, G.; Soto-Robles, C.A.; Nava, E.; Lugo-Medina, E. Principal Metabolites in Extracts of Different Plants Responsible for Antibacterial Effects. Chem. Res. Toxicol. 2021, 34, 1970–1983. [Google Scholar] [CrossRef]
- Bhatia, P.; Sharma, A.; George, A.J.; Anvitha, D.; Kumar, P.; Dwivedi, V.P.; Chandra, N.S. Antibacterial activity of medicinal plants against ESKAPE: An update. Heliyon 2021, 7, e06310. [Google Scholar] [CrossRef]
- Greff, B.; Sáhó, A.; Lakatos, E.; Varga, L. Biocontrol Activity of Aromatic and Medicinal Plants and Their Bioactive Components against Soil-Borne Pathogens. Plants 2023, 12, 706. [Google Scholar] [CrossRef] [PubMed]
- Archana, H.; Geetha Bose, V. Evaluation of phytoconstituents from selected medicinal plants and its synergistic antimicrobial activity. Chemosphere 2022, 287, 132276. [Google Scholar] [CrossRef] [PubMed]
- Anand, U.; Jacobo-Herrera, N.; Altemimi, A.; Lakhssassi, N. A Comprehensive Review on Medicinal Plants as Antimicrobial Therapeutics: Potential Avenues of Biocompatible Drug Discovery. Metabolites 2019, 9, 258. [Google Scholar] [CrossRef] [PubMed]
- Ashraf, M.V.; Pant, S.; Khan, M.A.H.; Shah, A.A.; Siddiqui, S.; Jeridi, M.; Alhamdi, H.W.S.; Ahmad, S. Phytochemicals as Antimicrobials: Prospecting Himalayan Medicinal Plants as Source of Alternate Medicine to Combat Antimicrobial Resistance. Pharmaceuticals 2023, 16, 881. [Google Scholar] [CrossRef] [PubMed]
- Di Lorenzo, C.; Colombo, F.; Biella, S.; Stockley, C.; Restani, P. Polyphenols and Human Health: The Role of Bioavailability. Nutrients 2021, 13, 273. [Google Scholar] [CrossRef] [PubMed]
- Vasudevan, P.; Tandon, M. Antimicrobial properties of iodine based products. J. Sci. Ind. Res. 2010, 69, 376–383. [Google Scholar]
- Bigliardi, P.L.; Alsagoff, S.A.L.; El-Kafrawi, H.Y.; Pyon, J.-K.; Wa, C.T.C.; Villa, M.A. Povidone iodine in wound healing: A review of current concepts and practices. Int. J. Surg. 2017, 44, 260–268. [Google Scholar] [CrossRef] [PubMed]
- Padalhin, A.; Ryu, H.S.; Yoo, S.H.; Abueva, C.; Seo, H.H.; Park, S.Y.; Chung, P.-S.; Woo, S.H. Antiseptic, Hemostatic, and Wound Activity of Poly(vinylpyrrolidone)-Iodine Gel with Trimethyl Chitosan. Int. J. Mol. Sci. 2024, 25, 2106. [Google Scholar] [CrossRef]
- Gillam, T.A.; Goh, C.K.; Ninan, N.; Bilimoria, K.; Shirazi, H.S.; Saboohi, S.; Al-Bataineh, S.; Whittle, J.; Blencowe, A. Iodine complexed poly(vinylpyrrolidone) plasma polymers as broad spectrum antiseptic coating. Appl. Surf. Sci. 2021, 537, 147866. [Google Scholar] [CrossRef]
- Xu, X.; Guan, Y. Investigating the Complexation and Release Behaviors of Iodine in Poly(vinylpyrrolidone)-Iodine Systems through Experimental and Computational Approaches. Ind. Eng. Chem. Res. 2020, 59, 22667–22676. [Google Scholar] [CrossRef]
- Gao, T.; Fan, H.; Wang, X.; Gao, Y.; Liu, W.; Chen, W.; Dong, A.; Wang, Y.J. Povidone-Iodine-Based Polymeric Nanoparticles for Antibacterial applications. ACS Appl. Mater. Interfaces 2017, 9, 25738–25746. [Google Scholar] [CrossRef]
- Dattilo, S.; Spitaleri, F.; Aleo, D.; Saita, M.G.; Patti, A. Solid-State Preparation and Characterization of 2-Hydroxypropylcyclodextrins-Iodine Complexes as Stable Iodophors. Biomolecules 2023, 13, 474. [Google Scholar] [CrossRef]
- Schmitz, G.; Rosenblatt, L.; Salerno, N.; Odette, J.; Ren, R.; Emanuel, T.; Michalek, J.; Liu, Q.; Du, L.; Jahangir, K.; et al. Treatment data using a topical povidone-iodine antiseptic in patients with superficial skin abscesses. Data Brief 2019, 23, 103715. [Google Scholar] [CrossRef] [PubMed]
- Ma, J.; Zhang, Y.; Zhang, D.; Niu, X.; Lin, Z. Insights into the molecular interaction between poly(vinylpyrrolidone)-iodine disinfection system and polypropylene microplastics in aquatic environment. Chem. Eng. J. 2022, 430, 132276. [Google Scholar] [CrossRef]
- Kaiho, T. Iodine Chemistry and Applications, 1st ed.; Kaiho, T., Ed.; John Wiley & Sons, Inc.: Hoboken, NJ, USA, 2015; pp. 15–410. ISBN 78-1-118-46629-2. [Google Scholar]
- Viswanathan, K.; Babu, D.B.; Jayakumar, G.; Raj, G.D. Anti-microbial and skin wound dressing application of molecular iodine nanoparticles. Mater. Res. Express 2017, 4, 104003. [Google Scholar] [CrossRef]
- Moulay, S. Macromolecule/Polymer-Iodine Complexes: An Update. Recent Innov. Chem. Eng. 2019, 12, 174. [Google Scholar] [CrossRef]
- Blake, A.J.; Li, W.S.; Lippolis, V.; Schröder, M.; Devillanova, F.A.; Gould, R.O.; Parsons, S.; Radek, C. Template self-assembly of polyiodide networks. Chem. Soc. Rev. 1998, 27, 195–206. [Google Scholar] [CrossRef]
- Savastano, M.; Bazzicalupi, C.; García, C.; Gellini, C.; López de la Torre, M.D.; Mariani, P.; Pichierri, F.; Bianchi, A.; Melguizo, M. Iodide and triiodide anion complexes involving anion–π interactions with a tetrazine-based receptor. Dalton Trans. 2017, 46, 4518. [Google Scholar] [CrossRef]
- Savastano, M. Words in supramolecular chemistry: The ineffable advances of polyiodide chemistry. Dalton Trans. 2021, 50, 1142–1165. [Google Scholar] [CrossRef]
- Van Megen, M.; Reiss, G.J. I62− Anion composed of two asymmetric triiodide moieties: A competition between halogen and hydrogen bond. Inorganics 2013, 1, 3–13. [Google Scholar] [CrossRef]
- Savastano, M.; Bazzicalupi, C.; Gellini, C.; Bianchi, A. Genesis of Complex Polyiodide Networks: Insights on the Blue Box/I−/I2 Ternary System. Crystals 2020, 10, 387. [Google Scholar] [CrossRef]
- Wang, M.; Takahama, T.; Tashiro, K. Crystalline Iodine Complexes of Amorphous Poly(vinyl acetate) as Studied by X-ray Diffraction, Vibrational Spectroscopy, and Computer Simulation. Macromolecules 2020, 53, 4395–4406. [Google Scholar] [CrossRef]
- Tashiro, K.; Takahama, T.; Wang, M.F. X-ray study of Poly(vinyl Alcohol)-Iodine complex prepared from the dilute iodine solution as a hint to know the inner structure of polarizer. Polymer 2021, 233, 124180. [Google Scholar] [CrossRef]
- Zhang, Q.; Wu, Z.; Liu, F.; Liu, S.; Liu, J.; Wang, Y.; Yan, T. Encapsulating a high content of iodine into an active graphene substrate as a cathode material for high-rate lithium–iodine batteries. J. Mater. Chem. A 2017, 5, 15235–15242. [Google Scholar] [CrossRef]
- Okuda, M.; Hiramatsu, T.; Yasuda, M.; Ishigaki, M.; Ozaki, Y.; Hayashi, M.; Tominaga, K.; Chatani, E. Theoretical Modeling of Electronic Structures of Polyiodide Species Included in α-Cyclodextrin. J. Phys. Chem. B 2020, 124, 4089–4096. [Google Scholar] [CrossRef]
- Shestimerova, T.A.; Mironov, A.V.; Bykov, M.A.; Grigorieva, A.V.; Wei, Z.; Dikarev, E.V.; Shevelkov, A.V. Assembling Polyiodides and Iodobismuthates Using a Template Effect of a Cyclic Diammonium Cation and Formation of a Low-Gap Hybrid Iodobismuthate with High Thermal Stability. Molecules 2020, 25, 2765. [Google Scholar] [CrossRef] [PubMed]
- Lundin, J.G.; McGann, C.L.; Weise, N.K.; Estrella, L.A.; Balow, R.B.; Streifel, B.C.; Wynne, J.H. Iodine binding and release from antimicrobial hemostatic polymer foams. React. Funct. Polym. 2019, 135, 44–51. [Google Scholar] [CrossRef]
- Yao, L.; Xu, P.; Gao, W.; Li, J.; Gao, L.; Niu, G.; Li, D.; Chen, S.; Tang, J. A chain-type diamine strategy towards strongly anisotropic triiodide of DMEDA·I6. Sci. China Mater. 2020, 63, 566–574. [Google Scholar] [CrossRef]
- Sai, M.; Zhong, S.; Tang, Y.; Ma, W.; Sun, Y.; Ding, D. Research on the preparation and antibacterial properties of 2-N-thiosemicarbazide-6-O-hydroxypropyl chitosan membranes with iodine. J. Appl. Polym. Sci. 2014, 131, 40535. [Google Scholar] [CrossRef]
- Ordinartsev, A.A.; Petrov, A.A.; Lyssenko, K.A.; Petrov, A.V.; Goodilin, E.A.; Tarasov, A.B. Crystal structure of new formamidinium triiodide jointly refined by single-crystal XRD, Raman scattering spectroscopy and DFT assessment of hydrogen-bond network features. Acta Cryst. 2021, 77, 692–695. [Google Scholar] [CrossRef]
- Edis, Z.; Bloukh, S.H.; Sara, H.A.; Bloukh, I.H. Green Synthesized Polymeric Iodophors with Thyme as Antimicrobial Agents. Int. J. Mol. Sci. 2024, 25, 1133. [Google Scholar] [CrossRef]
- Edis, Z.; Bloukh, S.H.; Sara, H.A.; Azelee, N.I.W. Antimicrobial Biomaterial on Sutures, Bandages and Face Masks with Potential for Infection Control. Polymers 2022, 14, 1932. [Google Scholar] [CrossRef]
- Bloukh, S.H.; Edis, Z.; Ibrahim, M.R.; Abu Sara, H. “Smart” antimicrobial nanocomplexes with potential to decrease surgical site infections (SSI). Pharmaceutics 2020, 12, 361. [Google Scholar] [CrossRef]
- Edis, Z.; Bloukh, S.H. Facile Synthesis of Bio-Antimicrobials with “Smart” Triiodides. Molecules 2021, 26, 3553. [Google Scholar] [CrossRef]
- Edis, Z.; Bloukh, S.H. Facile Synthesis of Antimicrobial Aloe Vera-“Smart” Triiodide-PVP Biomaterials. Biomimetics 2020, 5, 45. [Google Scholar] [CrossRef] [PubMed]
- Rahma, A.; Munir, M.M.; Khairurrijal, K.; Prasetyo, A.; Suendo, V.; Rachmawati, H. Intermolecular Interactions and the Release Pattern of Electrospun Curcumin-Polyvinyl (pyrrolidone) Fiber. Biol. Pharm. Bull. 2016, 39, 163–173. [Google Scholar] [CrossRef] [PubMed]
- Edis, Z.; Bloukh, S.H. Antimicrobial V-Shaped Copper(II) Pentaiodide: Insights to Bonding Pattern and Susceptibility. Molecules 2022, 27, 6437. [Google Scholar] [CrossRef] [PubMed]
- Edis, Z.; Raheja, R.; Bloukh, S.H.; Bhandare, R.R.; Sara, H.A.; Reiss, G.J. Antimicrobial Hexaaquacopper(II) Complexes with Novel Polyiodide Chains. Polymers 2021, 13, 1005. [Google Scholar] [CrossRef]
- Haj Bloukh, S.; Edis, Z. Halogen bonding in Crystal structure of bis(1,4,7,10-tetraoxacyclododecane-κ4O,O′,O″,O‴)cesium triiodide, C16H32CsI3O8. Z. Krist. New Cryst. Struct. 2020, 235, 717–719. [Google Scholar] [CrossRef]
- Edis, Z.; Haj Bloukh, S.; Abu Sara, H.; Bhakhoa, H.; Rhyman, L.; Ramasami, P. “Smart” triiodide compounds: Does halogen bonding influence antimicrobial activities? Pathogens 2019, 8, 182. [Google Scholar] [CrossRef]
- Edis, Z.; Bloukh, S.H. Preparation and structural and spectroscopic characterization of triiodides [M(12-crown-4)2]I3 with M = Na and Rb. Z. Nat. 2014, 69, 995–1002. [Google Scholar]
- Bloukh, S.H.; Edis, Z. Structure and Antimicrobial properties of bis(1,4,7,10-tetraoxacyclododecane-κ4O,O′,O″,O‴)cesium pentaiodide, C16H32CsI5O8. Z. Krist. New Cryst. Struct. 2020, 235, 759–761. [Google Scholar] [CrossRef]
- Edis, Z.; Bloukh, S.H. Preparation and structural and spectroscopic characterization of a pentaiodide [Rb(12-crown-4)2]I5. Z. Nat. 2013, 68, 1340–1346. [Google Scholar]
- Haj Bloukh, S.; Edis, Z.; Abu Sara, H.; Alhamaidah, M.A. Antimicrobial Properties of Lepidium sativum L. Facilitated Silver Nanoparticles. Pharmaceutics 2021, 13, 1352. [Google Scholar] [CrossRef]
- Reda, M.; Ashames, A.; Edis, Z.; Bloukh, S.; Bhandare, R.; Abu Sara, H. Green Synthesis of Potent Antimicrobial Silver Nanoparticles Using Different Plant Extracts and Their Mixtures. Processes 2019, 7, 510. [Google Scholar] [CrossRef]
- Ecevit, K.; Barros, A.A.; Silva, J.M.; Reis, R.L. Preventing microbial infections with natural phenolic compounds. Future Pharmacol. 2022, 2, 460–498. [Google Scholar] [CrossRef]
- Zemljič, L.F.; Plohl, O.; Vesel, A.; Luxbacher, T.; Potrč, S. Physicochemical Characterization of Packaging Foils Coated by Chitosan and Polyphenols Colloidal Formulations. Int. J. Mol. Sci. 2020, 21, 495. [Google Scholar] [CrossRef]
- Lopes, A.I.; Pintado, M.M.; Tavaria, F.K. Plant-Based Films and Hydrogels for Wound Healing. Microorganisms 2024, 12, 438. [Google Scholar] [CrossRef]
- Fierascu, R.C.; Fierascu, I.; Baroi, A.M.; Ortan, A. Selected Aspects Related to Medicinal and Aromatic Plants as Alternative Sources of Bioactive Compounds. Int. J. Mol. Sci. 2021, 22, 1521. [Google Scholar]
- Zielińska-Błajet, M.; Feder-Kubis, J. Monoterpenes and Their Derivatives—Recent Development in Biological and Medical Applications. Int. J. Mol. Sci. 2020, 21, 7078. [Google Scholar]
- Palmieri, S.; Pellegrini, M.; Ricci, A.; Compagnone, D.; Lo Sterzo, C. Chemical Composition and Antioxidant Activity of Thyme, Hemp and Coriander Extracts: A Comparison Study of Maceration, Soxhlet, UAE and RSLDE Techniques. Foods 2020, 9, 1221. [Google Scholar] [CrossRef]
- Duque-Soto, C.; Borrás-Linares, I.; Quirantes-Piné, R.; Falcó, I.; Sánchez, G.; Segura-Carretero, A.; Lozano-Sánchez, J. Potential Antioxidant and Antiviral Activities of Hydroethanolic Extracts of Selected Lamiaceae Species. Foods 2022, 11, 1862. [Google Scholar] [CrossRef] [PubMed]
- Vassiliou, E.; Awoleye, O.; Davis, A.; Mishra, S. Anti-Inflammatory and Antimicrobial Properties of Thyme Oil and Its Main Constituents. Int. J. Mol. Sci. 2023, 24, 6936. [Google Scholar] [CrossRef] [PubMed]
- Li, Y.X.; Erhunmwunsee, F.; Liu, M.; Yang, K.; Zheng, W.; Tian, J. Antimicrobial mechanisms of spice essential oils and application in food industry. Food Chem. 2022, 15, 132312. [Google Scholar] [CrossRef] [PubMed]
- Soleimani, M.; Arzani, A.; Arzani, V.; Roberts, T.H. Phenolic compounds and antimicrobial properties of mint and thyme. J. Herb. Med. 2022, 36, 100604. [Google Scholar] [CrossRef]
- Masek, A.; Cichosz, S.; Piotrowska, M. Comparison of Aging Resistance and Antimicrobial Properties of Ethylene–Norbornene Copolymer and Poly(Lactic Acid) Impregnated with Phytochemicals Embodied in Thyme (Thymus vulgaris) and Clove (Syzygium aromaticum). Int. J. Mol. Sci. 2021, 22, 13025. [Google Scholar] [CrossRef]
- Zhao, A.; Zhang, Y.; Li, F.; Chen, L.; Huang, X. Analysis of the Antibacterial Properties of Compound Essential Oil and the Main Antibacterial Components of Unilateral Essential Oils. Molecules 2023, 28, 6304. [Google Scholar] [CrossRef] [PubMed]
- Çimen, C.G.; Dündar, M.A.; Kars, M.D.; Avcı, A. Enhancement of PCL/PLA Electrospun Nanocomposite Fibers Comprising Silver Nanoparticles Encapsulated with Thymus vulgaris L. Molecules for Antibacterial and Anticancer Activities. ACS Biomater. Sci. Eng. 2022, 8, 3717–3732. [Google Scholar] [CrossRef] [PubMed]
- Althunibat, O.Y.; Qaralleh, H.; Yassin, S.; Al-Dalin, A.; Abboud, M.; Khleifat, K.; Majali, I.S.; Aldal’in, H.K.H.; Rayyan, W.A.; Jaafraa, A. Effect of thymol and carvacrol, the major components of Thymus capitatus on the growth of Pseudomonas aeruginosa. J. Pure Appl. Microbiol. 2016, 10, 367–374. [Google Scholar]
- Parolin, G.A.; Vital, V.G.; de Vasconcellos, S.P.; Lago, J.H.G.; Péres, L.O. Thymol as Starting Material for the Development of a Biobased Material with Enhanced Antimicrobial Activity: Synthesis, Characterization, and Potential Application. Molecules 2024, 29, 1010. [Google Scholar] [CrossRef]
- Memar, M.Y.; Raei, P.; Alizadeh, N.; Aghdam, M.A.; Kafil, H.S. Carvacrol and thymol: Strong antimicrobial agents against resistant isolates. Med. Microbiol. 2017, 28, 63–68. [Google Scholar] [CrossRef]
- Rojas, A.; Misic, D.; Dicastillo, C.L.; Zizovic, I.; Velásquez, E.; Gutiérrez, D.; Aguila, G.; Vidal, C.P.; Guarda, A.; Galotto, M.J. A review on thymol-based bioactive materials for food packaging. Ind. Crop Prod. 2023, 202, 116977. [Google Scholar] [CrossRef]
- Hajibonabi, A.; Yekani, M.; Sharifi, S.; Nahad, J.S.; Dizaj, S.M.; Memar, M.Y. Antimicrobial activity of nanoformulations of carvacrol and thymol: New trend and applications. OpenNano 2023, 13, 100170. [Google Scholar] [CrossRef]
- Escobar, A.; Perez, M.; Romanelli, G.; Blustein, G. Thymol bioactivity: A review focusing on practical applications. Arab. J. Chem. 2020, 13, 9243–9269. [Google Scholar] [CrossRef]
- Zhan, C.; Lian, L.; Pang, C.; Hong, L. Polymers with a Thymol End Group for Durable Antibacterial Cotton Fabrics. ACS Sustain. Resour. Manag. 2024, 1, 395–403. [Google Scholar] [CrossRef]
- Chittratan, P.; Chalitangkoon, J.; Wongsariya, K.; Mathaweesansurn, A.; Detsri, E.; Monvisade, P. New Chitosan-Grafted Thymol Coated on Gold Nanoparticles for Control of Cariogenic Bacteria in the Oral Cavity. ACS Omega 2022, 7, 26582–26590. [Google Scholar] [CrossRef]
- Zhou, W.; Wang, Z.; Mo, H.; Zhao, Y.; Li, H.; Zhang, H.; Hu, L.; Zhou, X. Thymol Mediates Bactericidal Activity against Staphylococcus aureus by Targeting an Aldo–Keto Reductase and Consequent Depletion of NADPH. J. Agric. Food Chem. 2019, 67, 8382–8392. [Google Scholar] [CrossRef]
- Mangiacapre, E.; Triolo, A.; Ramondo, F.; Lo Celso, F.; Russina, O. Unveiling the structural organisation of carvacrol through X-ray scattering and molecular Dynamics: A comparative study with liquid thymol. J. Mol. Liquids 2024, 394, 123778. [Google Scholar] [CrossRef]
- Di Pasqua, R.; Hoskins, N.; Betts, G.; Mauriello, G. Changes in membrane fatty acids composition of microbial cells induced by addiction of thymol, carvacrol, limonene, cinnamaldehyde, and eugenol in the growing media. J. Agric. Food Chem. 2006, 54, 2745–2749. [Google Scholar] [CrossRef]
- Nogueira, J.O.E.; Campolina, G.A.; Batista, L.R.; Alves, L.; Caetano, A.R.S.; Brandão, R.M.; Nelson, D.L.; Cardoso, M.D.G. Mechanism of action of various terpenes and phenylpropanoids against Escherichia coli and Staphylococcus aureus. FEMS Microbiol. Lett. 2021, 368, fnab052. [Google Scholar] [CrossRef]
- Wijesundara, N.M.; Lee, S.F.; Cheng, Z.; Davidson, R.; Langelaan, D.N.; Rupasinghe, H.P.V. Bactericidal Activity of Carvacrol against Streptococcus pyogenes Involves Alteration of Membrane Fluidity and Integrity through Interaction with Membrane Phospholipids. Pharmaceutics 2022, 14, 1992. [Google Scholar] [CrossRef] [PubMed]
- Sharma, K.; Munjal, M.; Sharma, R.K.; Sharma, M. Thymol encapsulated chitosan-Aloe vera films for antimicrobial infection. Int. J. Biol. Macromol. 2023, 235, 123897. [Google Scholar] [CrossRef] [PubMed]
- Lu, W.-C.; Chen, C.-Y.; Cho, C.-J.; Venkatesan, M.; Chiang, W.-H.; Yu, Y.-Y.; Lee, C.-H.; Lee, R.-H.; Rwei, S.-P.; Kuo, C.-C. Antibacterial Activity and Protection Efficiency of Polyvinyl Butyral Nanofibrous Membrane Containing Thymol Prepared through Vertical Electrospinning. Polymers 2021, 13, 1122. [Google Scholar] [CrossRef] [PubMed]
- Al-Nasiri, G.; Cran, M.J.; Smallridge, A.J.; Bigger, S.W. Optimisation of β-cyclodextrin inclusion complexes with natural antimicrobial agents: Thymol, carvacrol and linalool. J. Microencapsul. 2018, 35, 26–35. [Google Scholar] [CrossRef] [PubMed]
- Wijesundara, N.M.; Lee, S.F.; Cheng, Z.; Davidson, R.; Rupasinghe, H.P.V. Carvacrol exhibits rapid bactericidal activity against Streptococcus pyogenes through cell membrane damage. Sci. Rep. 2021, 11, 1487. [Google Scholar] [CrossRef] [PubMed]
- Ramos, M.; Jiménez, A.; Peltzer, M.; Garrigós, M.C. Characterization and antimicrobial activity studies of polypropylene films with carvacrol and thymol for active packaging. J. Food Eng. 2012, 109, 513–519. [Google Scholar] [CrossRef]
- Ricardo-Rodrigues, S.; Rouxinol, M.I.; Agulheiro-Santos, A.C.; Potes, M.E.; Laranjo, M.; Elias, M. The Antioxidant and Antibacterial Potential of Thyme and Clove Essential Oils for Meat Preservation—An Overview. Appl. Biosci. 2024, 3, 87–101. [Google Scholar] [CrossRef]
- Sánchez, M.; González-Burgos, E.; Iglesias, I.; Gómez-Serranillos, M.P. Pharmacological Update Properties of Aloe Vera and its Major Active Constituents. Molecules 2020, 25, 1324. [Google Scholar] [CrossRef] [PubMed]
- Figueiredo, L.C.; Figueiredo, N.F.; Cruz, D.F.d.; Baccelli, G.T.; Sarachini, G.E.; Bueno, M.R.; Feres, M.; Bueno-Silva, B. Propolis, Aloe Vera, Green Tea, Cranberry, Calendula, Myrrha and Salvia Properties against Periodontal Microorganisms. Microorganisms 2022, 10, 2172. [Google Scholar] [CrossRef]
- Andrea, B.; Dumitrița, R.; Florina, C.; Francisc, D.; Anastasia, V.; Sonia Socaci, S.; Adela, P. Comparative analysis of some bioactive compounds in leaves of different Aloe species. BMC Chem. 2020, 14, 67. [Google Scholar] [CrossRef]
- Chelu, M.; Popa, M.; Ozon, E.A.; Pandele Cusu, J.; Anastasescu, M.; Surdu, V.A.; Calderon Moreno, J.; Musuc, A.M. High-Content Aloe vera Based Hydrogels: Physicochemical and Pharmaceutical Properties. Polymers 2023, 15, 1312. [Google Scholar] [CrossRef] [PubMed]
- Liu, C.; Cui, Y.; Pi, F.; Cheng, Y.; Guo, Y.; Qian, H. Extraction, Purification, Structural Characteristics, Biological Activities and Pharmacological Applications of Acemannan, a Polysaccharide from Aloe vera: A Review. Molecules 2019, 24, 1554. [Google Scholar] [CrossRef]
- Donkor, A.; Donkor, M.N.; Kuubabongnaa, N. Evaluation of anti-infective potencies of formulated aloin A ointment and aloin A isolated from Aloe barbadensis Miller. BMC Chem. 2020, 14, 8. [Google Scholar] [CrossRef] [PubMed]
- Chelu, M.; Musuc, A.M.; Popa, M.; Calderon Moreno, J. Aloe vera-Based Hydrogels for Wound Healing: Properties and Therapeutic Effects. Gels 2023, 9, 539. [Google Scholar] [CrossRef] [PubMed]
- Nalimu, F.; Oloro, J.; Kahwa, I.; Ogwang, P.E. Review on the phytochemistry and toxicological profiles of Aloe vera and Aloe ferox. Future J. Pharm. Sci. 2021, 7, 145. [Google Scholar] [CrossRef] [PubMed]
- Chelu, M.; Musuc, A.M.; Aricov, L.; Ozon, E.A.; Iosageanu, A.; Stefan, L.M.; Prelipcean, A.-M.; Popa, M.; Moreno, J.C. Antibacterial Aloe vera Based Biocompatible Hydrogel for Use in Dermatological Applications. Int. J. Mol. Sci. 2023, 24, 3893. [Google Scholar] [CrossRef] [PubMed]
- Deng, S.; Chen, A.; Chen, W.; Lai, J.; Pei, Y.; Wen, J.; Yang, C.; Luo, J.; Zhang, J.; Lei, C.; et al. Fabrication of Biodegradable and Biocompatible Functional Polymers for Anti-Infection and Augmenting Wound Repair. Polymers 2023, 15, 120. [Google Scholar] [CrossRef] [PubMed]
- Andonegi, M.; Irastorza, A.; Izeta, A.; de la Caba, K.; Guerrero, P. Physicochemical and Biological Performance of Aloe Vera-Incorporated Native Collagen Films. Pharmaceutics 2020, 12, 1173. [Google Scholar] [CrossRef]
- Tummalapalli, M.; Berthet, M.; Verrier, B.; Deopura, B.L.; Alam, M.S.; Gupta, B. Composite wound dressings of pectin and gelatin with aloe vera and curcumin as bioactive agents. Int. J. Biol. Macromol. 2016, 82, 104–113. [Google Scholar] [CrossRef]
- Ryall, C.; Duarah, S.; Chen, S.; Yu, H.; Wen, J. Advancements in Skin Delivery of Natural Bioactive Products for Wound Management: A Brief Review of Two Decades. Pharmaceutics 2022, 14, 1072. [Google Scholar] [CrossRef]
- Goudarzi, M.; Fazeli, M.; Azad, M.; Seyedjavadi, S.S.; Mousavi, R. Aloe vera gel: Effective Therapeutic Agent against Multidrug-Resistant Pseudomonas aeruginosa Isolates Recovered from Burn Wound Infections. Chemother. Res. Pract. 2015, 2015, 639806. [Google Scholar] [CrossRef] [PubMed]
- Alven, S.; Khwaza, V.; Oyedeji, O.O.; Aderibigbe, B.A. Polymer-Based Scaffolds Loaded with Aloe vera Extract for the Treatment of Wounds. Pharmaceutics 2021, 13, 961. [Google Scholar] [CrossRef]
- Aghamohamadi, N.; Sanjani, N.S.; Majidi, R.F.; Nasrollahi, S.A. Preparation and characterization of Aloe vera acetate and electrospinning fibers as promising antibacterial properties materials. Mater. Sci. Eng. C 2019, 94, 445–452. [Google Scholar] [CrossRef] [PubMed]
- Khan, R.U.; Naz, S.; De Marzo, D.; Dimuccio, M.M.; Bozzo, G.; Tufarelli, V.; Losacco, C.; Ragni, M. Aloe vera: A Sustainable Green Alternative to Exclude Antibiotics in Modern Poultry Production. Antibiotics 2023, 12, 44. [Google Scholar] [CrossRef] [PubMed]
- Aziz, S.B.; Abdullah, O.G.; Hussein, S.A.; Ahmed, H.M. Effect of PVA Blending on Structural and Ion Transport Properties of CS:AgNt-Based Polymer Electrolyte Membrane. Polymers 2017, 9, 622. [Google Scholar] [CrossRef]
- Mondal, M.I.H.; Saha, J.; Rahman, M.A. Functional Applications of Aloe vera on Textiles: A Review. J. Polym. Environ. 2021, 29, 993–1009. [Google Scholar] [CrossRef]
- Wang, Y.; Xu, J.; Li, X.; Peng, Y.; Xing, Y.; Wang, P.; Ran, R.; Zhang, T. Antibacterial performances of silk fabric finished by aloe anthraquinones. J. Text. Inst. 2023, 114, 1007–1015. [Google Scholar] [CrossRef]
- Kuntić, V.; Pejic, N.; Mićić, S. Direct Spectrophotometric Determination of Hesperidin in Pharmaceutical Preparations. Acta Chim. Slov. 2012, 59, 436–441. [Google Scholar]
- Mamatha, G.; Rajulu, A.V.; Madhukar, K. In Situ Generation of Bimetallic Nanoparticles in Cotton Fabric Using Aloe Vera Leaf Extract, as a Reducing Agent. J. Nat. Fibers 2020, 17, 1121–1129. [Google Scholar] [CrossRef]
- Xiang, H.; Cao, F.; Ming, D.; Zheng, Y.; Dong, X.; Zhong, X.; Mu, D.; Li, B.; Zhong, L.; Cao, J.; et al. Aloe-emodin inhibits Staphylococcus aureus biofilms and extracellular protein production at the initial adhesion stage of biofilm development. Appl. Microbiol. Biotechnol. 2017, 101, 6671–6681. [Google Scholar] [CrossRef]
- Sadiq, U.; Gill, H.; Chandrapala, J. Temperature and pH Stability of Anthraquinones from Native Aloe vera Gel, Spray-Dried and Freeze-Dried Aloe vera Powders during Storage. Foods 2022, 11, 1613. [Google Scholar] [CrossRef]
- Borges-Argáez, R.; Chan-Balan, R.; Cetina-Montejo, L.; Ayora-Talavera, G.; Sansores-Peraza, P.; Gómez-Carballo, J.; Mirbella Cáceres-Farfán, M. In vitro evaluation of anthraquinones from Aloe vera (Aloe barbadensis Miller) roots and several derivatives against strains of influenza virus. Ind. Crops Prod. 2019, 132, 468–475. [Google Scholar] [CrossRef]
- Sun, Z.; Yu, C.; Wang, W.; Yu, G.; Zhang, T.; Zhang, L.; Zhang, J.; Wei, K. Aloe Polysaccharides Inhibit Influenza A Virus Infection—A Promising Natural Anti-flu Drug. Front. Microbiol. 2018, 9, 2338. [Google Scholar] [CrossRef] [PubMed]
- Baker, R.E.; Mahmud, A.S.; Miller, I.F.; Rajeev, M.; Rasambainarivo, F.; Rice, B.L.; Takahashi, S.; Tatem, A.J.; Wagner, C.E.; Wang, L.F.; et al. Infectious disease in an era of global change. Nat. Rev. Microbiol. 2022, 20, 193–205. [Google Scholar] [CrossRef]
- Joseph, B.; George, A.; Gopi, S.; Kalarikkal, N.; Thomas, S. Polymer sutures for simultaneous wound healing and drug delivery—A review. Int. J. Pharm. 2017, 524, 454–466. [Google Scholar] [CrossRef]
- Teno, J.; Pardo-Figuerez, M.; Evtoski, Z.; Prieto, C.; Cabedo, L.; Lagaron, J.M. Development of Ciprofloxacin-Loaded Electrospun Yarns of Application Interest as Antimicrobial Surgical Suture Materials. Pharmaceutics 2024, 16, 220. [Google Scholar] [CrossRef] [PubMed]
- Tuñón-Molina, A.; Takayama, K.; Redwan, E.M.; Uversky, V.N.; Andrés, J.; Serrano-Aroca, Á. Protective Face Masks: Current Status and Future Trends. ACS Appl. Mater. Interfaces 2021, 13, 56725–56751. [Google Scholar] [CrossRef]
- Chowdhury, M.A.; Shuvho, M.B.A.; Shahid, M.A.; Haque, A.K.M.M.; Kashem, M.A.; Lam, S.S.; Ong, H.C.; Uddin, M.A.; Mofijur, M. Prospect of Biobased Antiviral Face Mask to Limit the Coronavirus Outbreak. Environ. Res. 2021, 192, 110294. [Google Scholar] [CrossRef] [PubMed]
- Borojeni, I.A.; Gajewski, G.; Riahi, R.A. Application of Electrospun Nonwoven Fibers in Air Filters. Fibers 2022, 10, 15. [Google Scholar] [CrossRef]
- Jung, S.; Yang, J.-Y.; Byeon, E.-Y.; Kim, D.-G.; Lee, D.-G.; Ryoo, S.; Lee, S.; Shin, C.-W.; Jang, H.W.; Kim, H.J.; et al. Copper-Coated Polypropylene Filter Face Mask with SARS-CoV-2 Antiviral Ability. Polymers 2021, 13, 1367. [Google Scholar] [CrossRef]
- Takayama, K.; Tuñón-Molina, A.; Cano-Vicent, A.; Muramoto, Y.; Noda, T.; Aparicio-Collado, J.L.; Sabater i Serra, R.; Martí, M.; Serrano-Aroca, Á. Non-Woven Infection Prevention Fabrics Coated with Biobased Cranberry Extracts Inactivate Enveloped Viruses Such as SARS-CoV-2 and Multidrug-Resistant Bacteria. Int. J. Mol. Sci. 2021, 22, 12719. [Google Scholar] [CrossRef] [PubMed]
- Mani, J.S.; Johnson, J.B.; Steel, J.C.; Broszczak, D.A.; Neilsen, P.M.; Walsh, K.B.; Naiker, M. Natural product-derived phytochemicals as potential agents against coronaviruses: A review. Virus Res. 2020, 284, 197989. [Google Scholar] [CrossRef] [PubMed]
- Ray, S.S.; Lee, H.K.; Huyen, D.T.T.; Chen, S.-S.; Young-Nam Kwon, Y.-N. Microplastics waste in environment: A perspective on recycling issues from PPE kits and face masks during the COVID-19 pandemic. Environ. Technol. Innov. 2022, 26, 102290. [Google Scholar] [CrossRef]
- Weigelt, M.A.; Lev-Tov, H.A.; Tomic-Canic, M.; Lee, W.D.; Williams, R.; Strasfeld, D.; Kirsner, R.S.; Herman, I.M. Advanced Wound Diagnostics: Toward Transforming Wound Care into Precision Medicine. Adv. Wound Care 2022, 11, 330–359. [Google Scholar] [CrossRef] [PubMed]
- Liang, H.; Mirinejad, M.S.; Asefnejad, A.; Baharifar, H.; Saber-Samandari, S.; Toghraie, D.; Khandan, A. Fabrication of tragacanthin gum-carboxymethyl chitosan bio-nanocomposite wound dressing with silver-titanium nanoparticles using freeze-drying method. Mater. Chem. Phys. 2022, 279, 125770. [Google Scholar] [CrossRef]
- Bauer, A.W.; Perry, D.M.; Kirby, W.M.M. Single-disk antibiotic-sensitivity testing of staphylococci: An analysis of technique and results. AMA Arch. Intern. Med. 1959, 104, 208–216. [Google Scholar] [CrossRef]
- CLSI. Performance Standards for Antimicrobial Susceptibility Testing, 29th ed.; Clinical and Laboratory Standards Institute: Wayne, PA, USA, 2019; Volume 39. [Google Scholar]

| Group | AV-PVP-Thymol-I2 | [42] | [43] | [29] | [38] | [20] |
|---|---|---|---|---|---|---|
| I2 [I2….I−] | sh, w 80 * s 169 * νas w 189 * ν | m 85 * m 160 * νas | s 169νs | |||
| I3− [I-I-I−] | s 112ν1,s | s 112ν1,s | sh, w 61δdef sh, w 70ν2bend vs 110ν1,s vw 222+ 2ν1,s | sh 60δdef sh, w 75ν2bend s 110ν1,s vw 221 2ν1,s | 114ν1,s | vs 111νs |
| I3− [I-I….I−] | w 141ν3,as w 148ν3,as | w 141ν3,as w 145ν3,as | m 144ν3,as | m 144ν3,as | 144ν3,as | m 145νs |
| vw 345νas | vw 334νas | sh, vw 154ν3,as |
| Group | 1 | 2 | 3 | [42] | PVP-I2 | Thymol | [43] |
|---|---|---|---|---|---|---|---|
| I2 | 203 vs | 203 vs | 204 vs | 205 vs | 206 vs | ||
| I3− as [I-I-I−] I3− as [I-I….I−] | 292 s, sh, br 360 m, br | 292 s, sh, br 360 m, br | 289 s, br 359 s, br | 290 m, br 360 m, br | 290 s, br 359 s, br | ||
| I5− | 444 w, br | ||||||
| I− | 201 s | 201 sh, vs | 201 sh, vs | 202 sh | 202 vs | ||
| AV/Aloin | 208 vs | 208 s | 208 vs | 208 vs 230 sh | 206 vs | ||
| PVP | 207 sh 213 s, sh | 207 s 213 s, sh | 208 vs | 208 vs 209 sh 213 s,sh | 207 vs 210 vs 212 sh 215 sh | 201–205 ** 209 vs 211 br 215 sh | |
| 216 s, sh 218 s, sh | 216 s, sh 218 vs, sh | 216 s,sh 220 vs, sh | 217 sh | 217 sh 219 s, sh | |||
| 221 vs, sh 224 m, sh | 222 vs, sh 225 m, sh | 223 vs 224 sh | 224 sh | 221 s, sh 224 s 231 sh | |||
| PVP-I2 | 304 vw | 304 m, sh | 304 m, sh | 304 w, sh | 304 sh | 305 s, sh | |
| Thymol | 203 vs 207 vs 211 vs 218 s, sh 276 m | 203 s 204 vs 206 s 207 vs 209 vs 211 s 215 s 218 vs, sh 250–325 ** 282 s 328–440 ** | 205 s 209 s 212 vs 220 vs, sh 250–325 ** 282 s 328–440 ** | 202–220 ** 204 vs 206 s 207 vs 210 vs, sh 250–320 ** 277 ** 330–440 ** 415 br, vw | 203 s 205 s 207 s 209 vs 210 vs 216 s 220 s 277 m | 283 ** 340 m, sh |
| Ν1,2 (O–H)s,a ν (COOH)a | ν (C–H)a | ν (C-H)a | ν (C-H)s | ν (C=O)a | δ (C-H)a δ (CH2) δ (O-H) | ν (C-C) | ν (C-O) | ν (C-O) ν (C-N) | |
|---|---|---|---|---|---|---|---|---|---|
| A | 3480 vs 3464 vs 3425 vs 3362 vs 3235 v 3169 vs 3152 s, sh | 2990 vs | 2949 vs (PVP) | 2855 vs | 1759 vw, br 1659 vw, br | 1456 s δ(CH3)s,in-plane 1420 s δ(CH3)a,in-plane 885 s δ(CH2)twisting 882 s δ(CH2)twisting 878 s δ(CH2)twisting 804 m δ(C-H)out-of-plane 667 m δ(O-H) | 1381 vs 1331 m, br | 1275 m, br | 1153 w, sh ν (C-N) 1101 vs ν (C-O) 1069 vs ν (C-O) 1051 s ν (C-O) 1042 s ν (C-O) 1037 br ν (C-O) 1036 s ν (C-O) |
| B | 3480 vs 3464 vs 3425 vs 3362 vs 3235 vs 3169 vs 3152 s, sh | 2990 vs | 2953 s (PVP) | 2855 s | 1757 vw, br 1665 vw, br | 1456 s δ(CH3)s,in-plane 1420 s δ(CH3)a,in-plane 882 s δ(CH2)twisting 804 m δ(C-H)out-of-plane 667 m δ(O-H) | 1381 vs 1331 m, br | 1275 m, br | 1153 w, sh ν (C-N) 1095 s ν (C-O) 1071 vs ν (C-O) 1051 s ν (C-O) 1042 s ν (C-O) 1037 br ν (C-O) |
| C | 3480 vs 3464 vs 3425 vs 3362 vs 3235 vs 3169 vs 3152 s, sh | 2990 vs | 2953 vs (PVP) | 2855 vs | 1757 vw, br 1661 vw, br | 1456 s δ(CH3)s,in-plane 1420 s δ(CH3)a,in-plane 885 s δ(CH2)twisting 882 s δ(CH2)twisting 878 s δ(CH2)twisting 804 m δ(C-H)out-of-plane 667 m δ(O-H) | 1381 vs 1331 m, br | 1275 m, br | 1153 w, sh ν (C-N) 1099 vs ν (C-O) 1071 vs ν (C-O) 1051 s ν (C-O) 1042 s ν (C-O) 1037 br ν (C-O) 1036 s ν (C-O) |
| Group | AV-PVP- Thymol | AV-PVP- Thymol-I2 | [42] | [46] | [83] | [40] | [35] |
|---|---|---|---|---|---|---|---|
| I2 | - | - | - | - | - | 25 29 36 | 24.5 s 25 s 28 s 37 w 38 w 43 w |
| 46 m | |||||||
| PVP | 14.89 s 24.36 w | 14.89 vs 24.37 w | 14.89 s 24.37 w | 10 s 19 s, br | - | - | - |
| Thymol | 28.83 vw | 14.92 s, br 14.98 m, br | - | 11.8 w 15.8 w | - | - | |
| 24.42 vw | 24.43 vw | 24.43 vw | 16.6 vs | ||||
| 30.08 m | 30.08 s | 30.08 m | 18.7 vs | ||||
| 30.14 w | 30.14 w | 30.14 vw | 20.3 m 20.8 m | ||||
| 24 w 25.4 s | |||||||
| AV | 45.83 w 45.96 vw 49.95 vw 50.07 vw 62.53 vw 62.71 vw | 45.84 w 45.96 vw 49.95 vw 50.07 vw 62.54 vw 62.72 vw | 45.84 vw 45.95 vw 49.95 vw 62.57 vw | 14 s 21 s, br 22 s, br | 38.2 vs 44.4 m 64.9 w | - | - |
| Strain | Antibiotic | A | 1+ | 2+ | 3+ | S | B | MB | MW | KN95 |
|---|---|---|---|---|---|---|---|---|---|---|
| C. albicans WDCM 00054 | NY | 16 | 61 | 50 | 40 * | 15 | 30 | 66 | 84 | 80+ |
| S. aureus ATCC 25923 | G | 28 | 35 | 30 | 25 | 9 | 30 | 40 | 36 | 32 |
| B. subtilis WDCM 00003 | G | 21 | 32 | 24 | 19 | 6 | 40 | 30 | 36 | 30 |
| S. pyogenes ATCC 19615 | G | 25 | 27 | 21 | 15 | 2.1 | 23 | 23 | 23 | 24 |
| E. faecalis ATCC 29212 | G | 25 | 22 | 18 | 15 | 6 | 21 | 23 | 32 | 21 |
| S. pneumoniae ATCC 49619 | G | 18 | 24 | 23 | 15 | 2.1 | 23 | 20 | 23 | 25 |
| K. pneumoniae WDCM 00097 | G | 30 | 17 | 15 | 13 | 3 | 22 | 26 | 23 | 30 |
| E. coli WDCM 00013 | G | 23 | 19 | 16 | 13 | 3 | 22 | 26 | 35 | 23 |
| P. aeruginosa WDCM 00026 | G | 23 | 15 | 13 | 11 | 0 | 0 | 13 | 16 | 18 |
| P. mirabilis ATCC 29906 | G | 30 | 0 | 0 | 0 | 0 | 0 | 0 | 0 | 0 |
| Strain | Antibiotic | A | Me | 1+ | L25 | [42] | PVP-I2 | [46] | T |
|---|---|---|---|---|---|---|---|---|---|
| C. albicans WDCM 00054 | NY | 16 | 72 | 61 | 30 | 60+ | 27 | 56 | 45 |
| S. aureus ATCC 25923 | G | 28 | 19 | 35 | 14 | 22 | 13 | 25 | 43 |
| B. subtilis WDCM 00003 | G | 21 | 10 | 32 | 11 | 19 | 13 | 22 | 40 |
| S. pyogenes ATCC 19615 | G | 25 | 16 | 27 | 10 | 16 | 12 | 16 | 29 |
| E. faecalis ATCC 29212 | G | 25 | 16 | 22 | 10 | 15 | 13 | 17 | 23 |
| S. pneumoniae ATCC 49619 | G | 18 | 14 | 24 | 9 | 15 | 13 | 14 | 0 |
| K. pneumoniae WDCM 00097 | G | 30 | 12 | 17 | 9 | 14 | 8 | 23 | 39 |
| E. coli WDCM 00013 | G | 23 | 12 | 19 | 9 | 14 | 10 | 18 | 34 |
| P. aeruginosa WDCM 00026 | G | 23 | 0 | 15 | 0 | 8 | 0 | 13 | 0 |
| P. mirabilis ATCC 29906 | G | 30 | 0 | 0 | 0 | 0 | 0 | 0 | 0 |
Disclaimer/Publisher’s Note: The statements, opinions and data contained in all publications are solely those of the individual author(s) and contributor(s) and not of MDPI and/or the editor(s). MDPI and/or the editor(s) disclaim responsibility for any injury to people or property resulting from any ideas, methods, instructions or products referred to in the content. |
© 2024 by the authors. Licensee MDPI, Basel, Switzerland. This article is an open access article distributed under the terms and conditions of the Creative Commons Attribution (CC BY) license (https://creativecommons.org/licenses/by/4.0/).
Share and Cite
Edis, Z.; Bloukh, S.H. Thymol, a Monoterpenoid within Polymeric Iodophor Formulations and Their Antimicrobial Activities. Int. J. Mol. Sci. 2024, 25, 4949. https://doi.org/10.3390/ijms25094949
Edis Z, Bloukh SH. Thymol, a Monoterpenoid within Polymeric Iodophor Formulations and Their Antimicrobial Activities. International Journal of Molecular Sciences. 2024; 25(9):4949. https://doi.org/10.3390/ijms25094949
Chicago/Turabian StyleEdis, Zehra, and Samir Haj Bloukh. 2024. "Thymol, a Monoterpenoid within Polymeric Iodophor Formulations and Their Antimicrobial Activities" International Journal of Molecular Sciences 25, no. 9: 4949. https://doi.org/10.3390/ijms25094949
APA StyleEdis, Z., & Bloukh, S. H. (2024). Thymol, a Monoterpenoid within Polymeric Iodophor Formulations and Their Antimicrobial Activities. International Journal of Molecular Sciences, 25(9), 4949. https://doi.org/10.3390/ijms25094949
